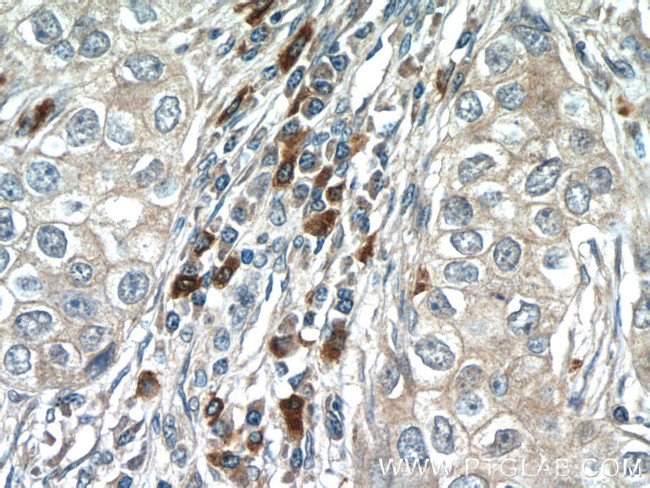
IRF1 Antibody in Immunohistochemistry (Paraffin) (IHC (P))

Search
Proteintech
IRF1 Polyclonal Antibody
{{$productOrderCtrl.translations['antibody.pdp.commerceCard.promotion.promotions']}}
{{$productOrderCtrl.translations['antibody.pdp.commerceCard.promotion.viewpromo']}}
{{$productOrderCtrl.translations['antibody.pdp.commerceCard.promotion.promocode']}}: {{promo.promoCode}} {{promo.promoTitle}} {{promo.promoDescription}}. {{$productOrderCtrl.translations['antibody.pdp.commerceCard.promotion.learnmore']}}
产品信息
11335-1-AP
种属反应
已发表种属
宿主/亚型
分类
类型
抗原
偶联物
形式
浓度
规格
纯化类型
保存液
内含物
保存条件
运输条件
产品详细信息
Immunogen sequence: MPITRMRMR PWLEMQINSN QIPGLIWINK EEMIFQIPWK HAAKHGWDIN KDACLFRSWA IHTGRYKAGE KEPDPKTWKA NFRCAMNSLP DIEEVKDQSR NKGSSAVRVY RMLPPLTKNQ RKERKSKSSR DAKSKAKRKS CGDSSPDTFS DGLSSSTLPD DHSSYTVPGY MQDLEVEQAL TPALSPCAVS STLPDWHIPV EVVPDSTSDL YNFQVSPMPS TSEATTDEDE EGKLPEDIMK LLEQSEWQPT NVDGKGYLLN EPGVQPTSVY GDFSCKEEPE IDSPGGDIGL SLQRVFTDLK NMDATWLDSL LTPVRLPSIQ AIPCAP (1-325 aa encoded by B C009483)
靶标信息
IRF1 encodes interferon regulatory factor 1, a member of the interferon regulatory transcription factor (IRF) family. IRF1 serves as an activator of interferons alpha and beta transcription, and in mouse it has been shown to be required for double-stranded RNA induction of these genes. IRF1 also functions as a transcription activator of genes induced by interferons alpha, beta, and gamma. Further, IRF1 has been shown to play roles in regulating apoptosis and tumor-suppression. Diseases associated with IRF1 include gastric cancer, somatic and lung cancer.
仅用于科研。不用于诊断过程。未经明确授权不得转售。
生物信息学
蛋白别名: Interferon regulatory factor 1; IRF-1; IRF1; translated product has a 124 residue deletion in the C-terminal compared to NP002189.1; translated product has a 158 residue deletion in the C-terminal compared to NP002189.1; unnamed protein product
基因别名: AU020929; IMD117; IRF-1; IRF1; MAR
UniProt ID: (Human) P10914, (Mouse) P15314, (Rat) P23570
Entrez Gene ID: (Human) 3659, (Mouse) 16362, (Rat) 24508